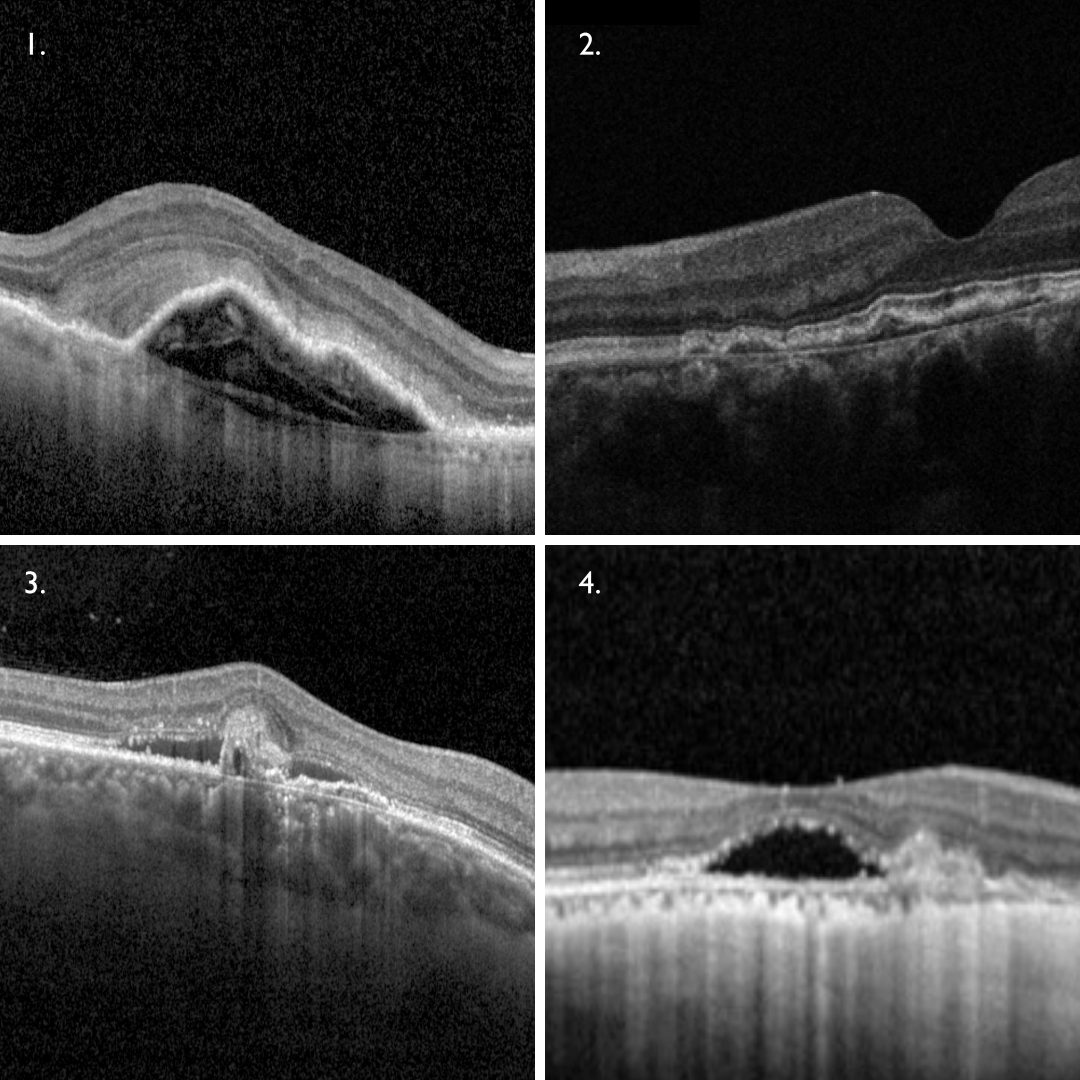

Overview
The term choroidal neovascularisation (CNV) refers to the growth of new blood vessels originating from the choroid. These vessels can either grow between the RPE and Bruch’s membrane (type 1 CNV) or in the space between the neurosensory retina and the RPE (type 2 CNV). These first two types can also occur in combination. Type 3 CNV, also know as retinal angiomatous proliferation (RAP), refers to neovascularisation within the retina.
Type 1 CNV is most commonly seen in both age-related macular degeneration (AMD) and pachychoroid disease spectrum.
- In AMD, the CNV breaks through Bruch’s membrane, sending branches out laterally underneath the RPE, elevating this layer (1).
- In pachychoroid disease, Type 1 CNV can occur in chronic CSCR, pachychoroid neovasculopathy (2) and polypoidal choroidal vasculopathy (3). In these cases, the choroidal neovascular membrane lies within a flat, irregular pigment epithelial detachment (FIPED) on OCT imaging. In cases of polypoidal choroidal vasculopathy, additional findings such as a sharp peaked PED and subretinal or intraretinal fluid can be seen.
Myopic CNV is a common form of Type 2 CNV with the neovascular network proliferating into the subretinal space. It appears as a highly reflective area above the RPE (4). There is typically minimal subretinal fluid associated with this type of neovascularisation.
Apart from the conditions mentioned above, CNV can occur in many other conditions. Below are links to the conditions commonly associated with CNV.